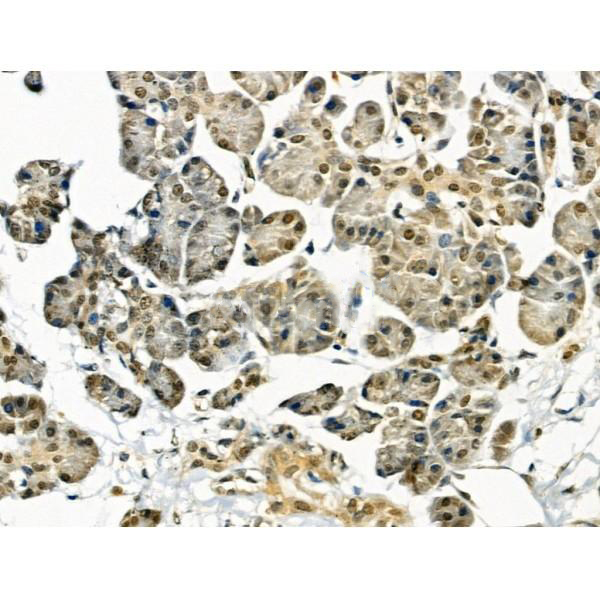

Anchoring protein that mediates the subcellular compartmentation of cAMP-dependent protein kinase (PKA type II). Acts as an anchor for a PKA-signaling complex onto mitotic chromosomes, which is required for maintenance of chromosomes in a condensed form throughout mitosis. Recruits condensin complex subunit NCAPD2 to chromosomes required for chromatin condensation; the function appears to be independent from PKA-anchoring. May help to deliver cyclin D/E to CDK4 to facilitate cell cycle progression. Required for cell cycle G2/M transition and histone deacetylation during mitosis. In mitotic cells recruits HDAC3 to the vicinity of chromatin leading to deacetylation and subsequent phosphorylation at 'Ser-10' of histone H3; in this function may act redundantly with AKAP8L. Involved in nuclear retention of RPS6KA1 upon ERK activation thus inducing cell proliferation. May be involved in regulation of DNA replication by acting as scaffold for MCM2. Enhances HMT activity of the KMT2 family MLL4/WBP7 complex and is involved in transcriptional regulation. In a teratocarcinoma cell line is involved in retinoic acid-mediated induction of developmental genes implicating H3 'Lys-4' methylation. May be involved in recruitment of active CASP3 to the nucleus in apoptotic cells. May act as a carrier protein of GJA1 for its transport to the nucleus. Seems to involved in modulation of rDNA transcription. Preferentially binds GC-rich DNA in vitro and associates to GC-rich ribosomal RNA promoters. Involved in modulation of Toll-like receptor signaling. Required for the cAMP-dependent suppression of TNF-alpha in early stages of LPS-induced macrophage activation; the function probably implicates targeting of PKA to NFKB1 (By similarity).
Description
Rabbit polyclonal antibody to AKAP8
Applications
WB, IF, ICC, IHC.
Immunogen
AKAP8 Antibody detects endogenous levels of total AKAP8.
Reactivity
Human, Mouse, Rat.
可预测:Bovine(100%), Horse(%), Sheep(%), Dog(%)
Molecular weight
76kDa; 76kD(Calculated).
Host species
Rabbit
Ig class
Immunogen-specific rabbit IgG
Purification
Antigen affinity purification
Full name
AKAP8
Synonyms
A kinase (PRKA) anchor protein 8; A kinase anchor protein 8; A kinase anchor protein 95; A kinase anchor protein 95 kDa; A kinase anchor protein 95kDa; A-kinase anchor protein 8; A-kinase anchor protein 95 kDa; AKAP 8; AKAP 95; AKAP-8; AKAP-95; Akap8; AKAP8_HUMAN; AKAP95; DKFZp586B1222;
Storage
Rabbit IgG in phosphate buffered saline , pH 7.4, 150mM NaCl, 0.02% sodium azide and 50% glycerol. Store at -20 °C. Stable for 12 months from date of receipt.
Swissprot
O43823




 产品订购:
产品订购:
 渠道电话:
渠道电话: